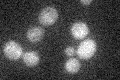
YOL063C
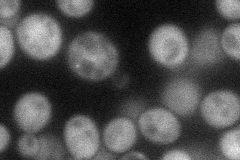
YOL063C
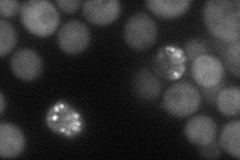
YOL063C
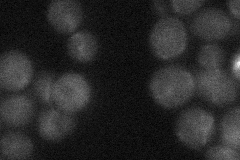
YOL063C
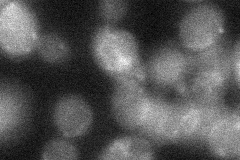
YOL063C
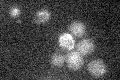
YOL063C

View description
Protein involved in transcriptional regulation of RNR2 and RNR3; expression of the gene is induced by DNA damage and null mutations confer increased resistance to hydroxyurea; N-terminal region has a leucine repeat and a WD40 repeat
Localization:
Intensity:
Fold change:
Significance:
-
C’ GFP library in SD
below threshold14.75 -
N' NOP1pr-GFP in SD
cytosol42.4359 -
N' TEF2pr-mCherry in SD
cytosol39.319 -
N' NATIVEpr-GFP in SD
below threshold21.4452 -
N' TEF2pr-VC and Cyto-VN in SD
cytosol28.7603 -
C’ GFP library in SD+DTT

cytosol17.971.21No -
C’ GFP library in SD+H2O2

cytosol13.80.93No -
C’ GFP library in Starvation Media
cytosol16.781.13No -
C’ GFP library on the background of Pup2-DaMP

below threshold -
C’ GFP library on the background of CCT mutant

below threshold15.85781.07443No
